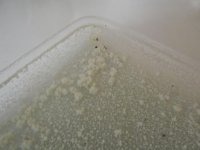
DSCF0858.JPG

So I decided to do Q21Q21’s tek and here are some pictures, cos I know how much you guys like them, to see how it all went.
After I heard about some people having problem with this tek I was not sure what amount to start with but then I decided to go for 100g of MHRB
It is not really very difficult to do but one think is very important as I found out and that is to get right consistency before you start with pulls. On the picture number six you see the right consistency. Make sure you get it right and you will pull nice white beautiful fluffy spice. You get it wrong and you will get into a problem to get the naphtha out of your jar, like I had before I corrected my mistake.
Just remember if it’s too muddy you will get into trouble. As I found out its better a bit on the dry site then too wet.
I have only done two pulls so far. First pull was 500mg and second 350mg. I have a feeling that there should be still more spice in there.
I will update once I have done more pulls.
After I heard about some people having problem with this tek I was not sure what amount to start with but then I decided to go for 100g of MHRB
It is not really very difficult to do but one think is very important as I found out and that is to get right consistency before you start with pulls. On the picture number six you see the right consistency. Make sure you get it right and you will pull nice white beautiful fluffy spice. You get it wrong and you will get into a problem to get the naphtha out of your jar, like I had before I corrected my mistake.
Just remember if it’s too muddy you will get into trouble. As I found out its better a bit on the dry site then too wet.
I have only done two pulls so far. First pull was 500mg and second 350mg. I have a feeling that there should be still more spice in there.
I will update once I have done more pulls.